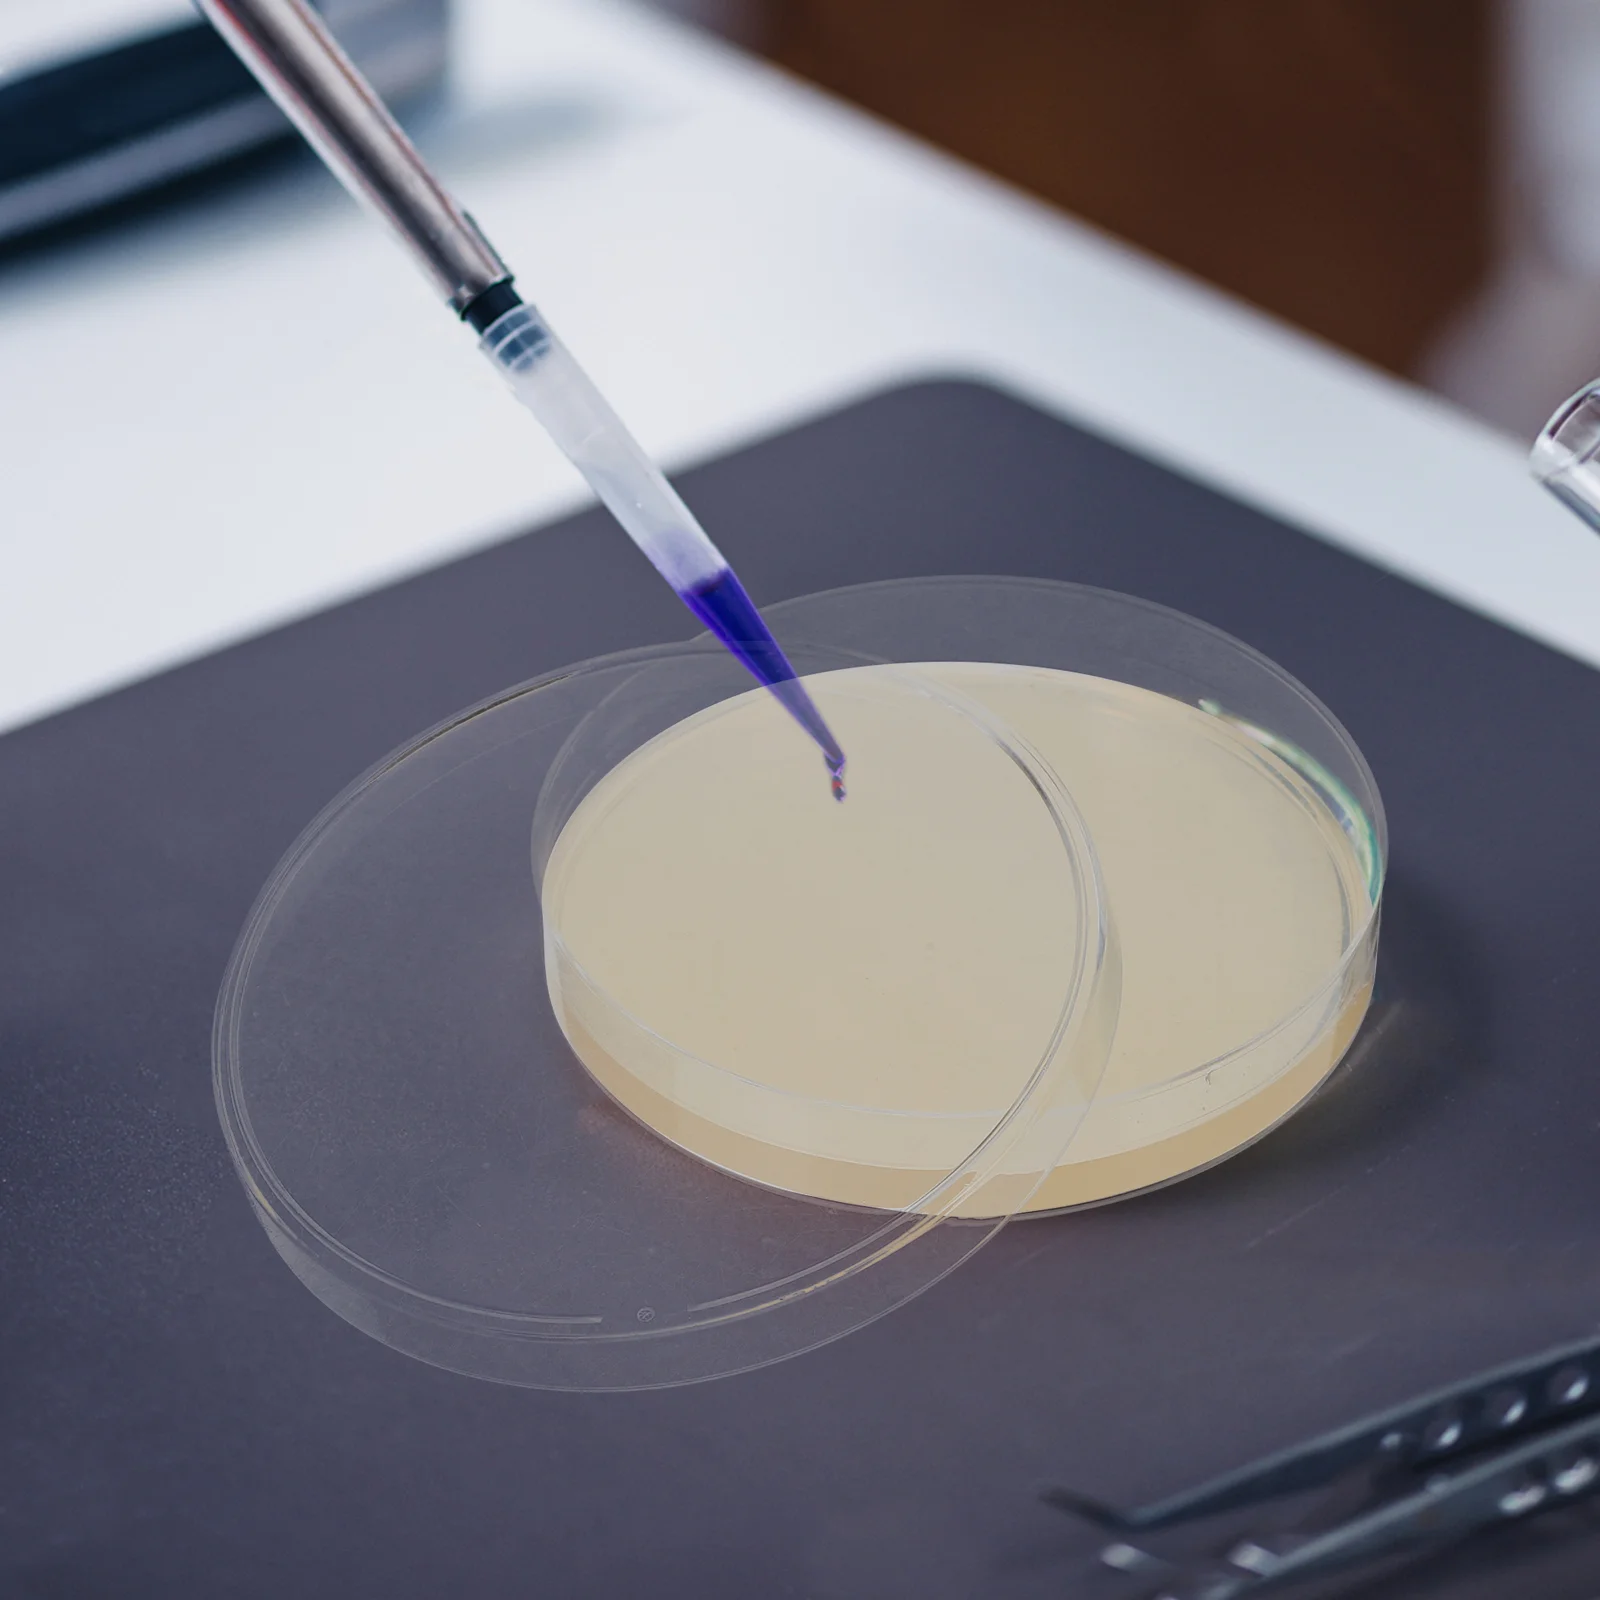

Высококачественный эксцентриковый Вихревой смеситель с бесщеточным двигателем
5823
Новое поступление

Магазина Shop1104073825 Store работает с 20.08.2024. его рейтинг составлет 0 баллов из 100. В избранное добавили 0 покупателя. Средний рейтинг торваров продавца 0 в продаже представленно 5982 наименований товаров, успешно доставлено 1 заказов. 0 покупателей оставили отзывы о продавце.
Характеристики
*Текущая стоимость 693 уже могла изменится. Что бы узнать актуальную цену и проверить наличие товара, нажмите "Добавить в корзину"
| Месяц | Минимальная цена | Макс. стоимость | Цена |
|---|---|---|---|
| Aug-15-2025 | 880.3 руб. | 898.61 руб. | 889 руб. |
| Jul-15-2025 | 714.11 руб. | 728.70 руб. | 721 руб. |
| Jun-15-2025 | 866.61 руб. | 883.60 руб. | 874.5 руб. |
| May-15-2025 | 859.32 руб. | 876.91 руб. | 867.5 руб. |
| Apr-15-2025 | 686.22 руб. | 700.24 руб. | 693 руб. |
| Mar-15-2025 | 845.17 руб. | 862.43 руб. | 853.5 руб. |
| Feb-15-2025 | 839.66 руб. | 856.80 руб. | 847.5 руб. |
| Jan-15-2025 | 832.77 руб. | 849.53 руб. | 840.5 руб. |
Описание товара

Смотрите так же другие товары: